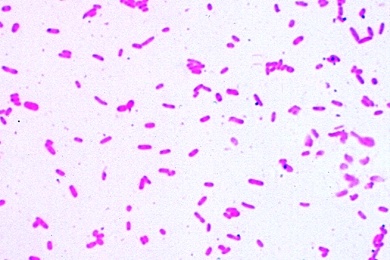
Mikropräparat - Säureliebende Bodenbakterien, Lösung von Schwermetallen im Boden

Unsere Umwelt III. Der Boden, Bodenleben und Bodenstruktur 17 Präparate mit ausführlichem Begleittext --
4571d Säureliebende Bodenbakterien, Lösung v. Schwermetallen im Boden - 4572d Nitritbildende Bodenbakterien, Bildung von schädlichen Stickstoffverbindungen -
4573d Wurzel der Buche mit ektotrophen Mykorrhiza, Querschnitt mitintakten Pilzhyphen - 4574d Wurzel der Birke mit teilweise endotrophen Mykorrhiza, quer - 4575d Wurzel der Lupine mit symbiontischen, stickstoffbindenden Bakterien, quer - 4576d Verrottendes Laubblatt, Äderung. Humusbildung -
4577c Ackersenf (Sinapis), Stengel quer, Gründüngepflanze - 4578d Bodenbakterien (Bacillus megaterium), Ausstrich -
4579d Baumwurzel mit Pilzhülle, quer. Wurzelpilze - 4580d Flechte, quer. Schadstoffanzeiger
4581c Maronenpilz (Xerocomus), Fuß mit Pilzmyzel, quer - 4582c Wurzel der Weide, quer. Erosionsschutz-Anpflanzung -
4583c Regenwurm (Lumbricus), quer. Bodenverbesserer - 4584d Springschwänze (Collembolen), Bodenbewohner -
4585d Milben aus dem Waldboden - 4586c Bestandteile des Humusbodens -
4587c Bestandteile saurer Moorböden --
Alle Präparate können einzeln bezogen werden. Verschiedene Präparate bereiten von der Beschaffung und Verarbeitung des Ausgangsmaterials her besondere Schwierigkeiten und können deshalb oft nur mit längerer Lieferzeit hergestellt werden.
Zubehör: - Präparatekasten aus Kunststoff für 25 Präparate - wird bei Ihrer Bestellung automatisch mit geliefert und separat berechnet. (PK25)
Verifizierter Kauf *
Geschrieben von Ralf D. am 29.04.2018
!!! Überzeugt !!!
Wie ich es mir gemäß Beschreibung vorgestellt hatte
Herstellerkennzeichnung
Herstellerkennzeichnung
Name: Johannes Lieder GmbH & Co. KGPostleitzahl: Ludwigsburg
Telefonnummer: +49 7141 921919